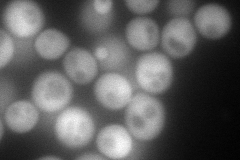
YLR380W
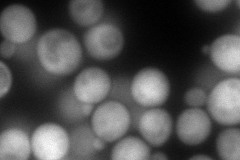
YLR380W
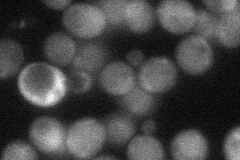
YLR380W
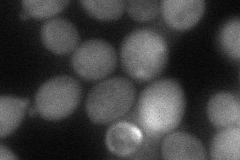
YLR380W
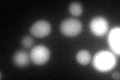
YLR380W

View description
Phosphatidylinositol transfer protein with a potential role in regulating lipid and fatty acid metabolism under heme-depleted conditions; interacts specifically with thioredoxin peroxidase; may have a role in oxidative stress resistance
Localization:
Intensity:
Fold change:
Significance:
-
C’ GFP library in SD

cytosol53.16 -
N' NOP1pr-GFP in SD
cytosol162.602 -
N' TEF2pr-mCherry in SD
cytosol197.13 -
N' NATIVEpr-GFP in SD
cytosol38.5547 -
N' TEF2pr-VC and Cyto-VN in SD
cytosol65.04 -
C’ GFP library in SD+DTT
cytosol53.731.01No -
C’ GFP library in SD+H2O2

cytosol50.80.95No -
C’ GFP library in Starvation Media

cytosol48.120.9No -
C’ GFP library on the background of Pup2-DaMP

cytosol -
C’ GFP library on the background of CCT mutant

cytosol49.43920.929801No
